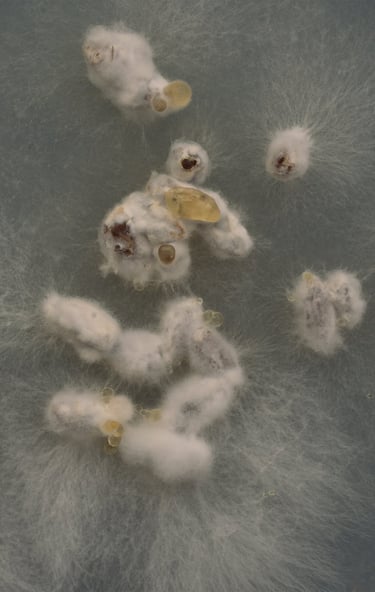
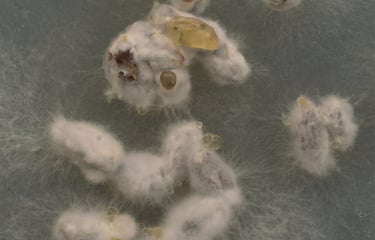

Masterclasses
AVAL er en platform for et kunstnerisk bæredygtigt fællesskab og vidensdeling. Til Masterclasses inviteres kunstnere, eksperter og andre interessante aktører til formidle og dele af deres viden og arbejde om handler om bæredygtighed og kunst. Hold øje med vores kalender eller tilmeld dig vores nyhedsbrev for kommende Masterclasses og andre arrangementerar
Kommende Masterclasses
Hold øje med kalenderen for at se kommende arrangementer i det nye år.
Afholdte Masterclasses
I denne workshop vil billedkunstner Pernille Emilia Kjær give en introduktion til at arbejde med mycelium, både som biomateriale og samarbejdspartner i den kunstneriske produktion. Vi vil gennemgå de mest basale, low-tech fremgangsmåder for dyrkning af svampe; herunder alt fra simple afstøbningsteknikker, til mini drivhuse, myceliums "malerier" på agarplader m.m. Der vil samtidig være plads til at eksperimentere og udvikle nye metoder i fællesskab.
Mycelium er ikke blot et fysisk materiale, men en måde at tænke på, i forlængelse af en anden levende organisme. Det er en proces der kalder på at følge vækstens langsommelighed og zoome ind på de rhizomatiske netværk vi indgår i.
Svampe findes overalt omkring os, men for det meste ænser vi knapt deres tilstedeværelse. Som gærsvampen der breder sig over vores hud, eller de underjordiske netværk af mycelium der forbinder skovens træer, i en gensidig udveksling af næringsstoffer og signaler. De trives i symbiosen, disse ældgamle organismer og med sig bærer de også et bæredygtigt fremtidspotentiale.
Pernille Emilia Kjær på Instagram: @pernille.emilia.kjaer
Sted: ved Det Bæredygtige Forsamlingshus, Bygning 46, Vej 10, nr. 18, Hospitalshaven, FrederiksbergGoogle map: Vej 10 18, Frederiksberg
Masterclass: Rhizomatiske formationer: Introduktion til mycelium som materiale og kunstnerisk metode af Pernille Emilia Kjær
04 dec 2025 kl. 17:00 - 19:00

Denne Masterclass der afholdes i Orangeriet, baserer sig på tre principper; at vi passer på jorden, at vi passer på os selv fysisk og mentalt både individuelt og socialt. Endeligt at vi sørger for en retfærdig fordeling af viden, mad og energi mellem mennesker og jorden. Vi vil i fællesskab og igennem forskellige øvelser lytte, lugte, smage, kigge, røre stedet … og undersøge hvordan det berører os. Workshoppen er en gymnastikøvelse i at være opmærksom og at kunne give og tage.
Denne Masterclass ledes af Arendse Krabbe: http://schizovibrant.net
STED: Orangeriet i Frederiksberg Fælleshave ved Det Bæredygtige Forsamlingshus, Hospitalshaven
Tilmelding via: Billetto
For medlemmer: Skriv til os på aval.hospitalshaven@gmail.com og tilmeld dig gratis til denne Masterclass.
Masterclass: Favntag af Arendse Krabbe
Tirsdag d.28 Oktober kl. 17.00-19.00


Denne masterclass søger at udforske, hvordan bæredygtighed kan forstås som en materialitet i sig selv, og hvad dette perspektiv tilbyder. Vi vil denne gang fokusere på den flydende farve, og farven som natur- og kulturbærende fænomen. Ved at fremstille blækfarver af lokale materialer undersøger vi ved workshoppen hvilke nye betydningslag der kan udfoldes, og hvilke nye associationer der opstår ved denne undersøgelse af grundlæggende materialitet.
Under workshoppen vil deltagerne blive introduceret til forskellige teknikker til at udvinde farver fra nære og lettilgængelige materialer, som vi omgiver os med i hverdagen – for eksempel brændenælder, løgskaller, frugtkerner, jord eller rustne søm. Samtidig ønsker vi at facilitere en fælles samtale om farvens fænomenologi: Hvordan farver fremtræder for os i vores bevidsthed, og hvordan vi oplever dem i vores interaktion med verden. Dette sker med en filosofisk tilgang, der lægger vægt på den subjektive erfaring af farver. Selve farve-fremstillingen tager udgangspunkt i bøgerne Make Ink A Forager’S Guide To Natural Inkmaking og Book Of Earth A Guide To Ochre, Pigment, And Raw Color.
Workshoppen er eksperimenterende og deltagerbaseret og fokuserer på at samle vores kollektive erfaringer og forståelser, afprøve, eksperimentere og udvide forståelser af farve som et bæredygtigt kunstnerisk materiale.
Målet er, ligesom ved en række af Aval’s øvrige workshops, at sætte gang i en proces, hvor vi i fællesskab udforsker og deler kunstnerisk viden og erfaringer.
Denne Masterclass ledes af Veronica Rigét: https://www.instagram.com/veronicariget/?hl=en
STED: Ved Det Bæredygtige Forsamlingshus, Bygning 46, Vej 10, nr. 18 i Hospitalshaven på Frederiksberg – BEMÆRK AT DET ER I NYE LOKALER
Tilmelding via: Billetto
For medlemmer: Skriv til os på aval.hospitalshaven@gmail.com og tilmeld dig gratis til denne Masterclass.
Lørdag d.27 September kl. 14.00-17.00


Masterclass: Farvens Fænomenologi og Fremstilling af Veronica Rigét
-----------------------------------------------------------




























Masterclass i hjemmelavet papir af grafiker og billedkunstner Karin Foxvig




















Lørdag d.17/5 kl. 13-16.30 + Søndag d. 18/5 kl. 13-16.30
Kom og vær med til at støbe dit eget papir fra grunden! Man starter med at rive en del genbrugspapir i stumper, dette lægges så i vand natten over, derefter blender man stumperne sammen med tørrede blade og blomster (som også har ligget i blød). Denne masse blandes med en masse vand, og man støber et stykke papir mellem to rammer, som så lægges ud på et stykke stof, som derefter hænges til tørre!
På grund af processen finder laboratorieworkshoppen sted over to dage i en weekend:
Lørdag d.17/5 kl. 13-16.30 samt Søndag d. 18/5 kl. 13-16.30
Sted: Det Bæredygtige Forsamlingshus, Vej 10 nummer 6 i Hospitalshaven på Frederiksberg.
Hjemmeside: detbaeredygtigeforsamlingshus.dk
Tilmelding via Billetto: laboratorieworkshop i hjemmelavet genbrugspapir
-----------------------------------------------------------
At bevidst bruge sine ressourcer på at samle, lede og forarbejde i stedet for ny-indkøb, stiller spørgsmål til den måde vi bruger tid og hvad vi anser for værdifuldt på.
Masterclassen finder sted over to dage af en times varighed:
Første del onsdag 2. april 2025 17-18: Rundvisning og introduktion til projekt Bispeorganisme* og forskellige måder at samle og finde på.
Sted : I indsamlingslokalet På Bispebjerg Hospital (nærmere oplysning fås ved tilmelding).
Anden del onsdag 9. april 2025 17-18: Vi mødes og ser på hvad og hvordan folk har samlet, snakker om kortlægning, samlinger, materialer, fragmenter.
Sted : Den Bæredygtige Forsamlingshus**, Vej 10 nummer 6 i Hospitalshaven på Frederiksberg.
*Bispeorganisme: Et (foreløbigt) 10 års stedsspecifikt bygningsintegreret kunstværk, hvor en stor del af projektet er at have værksted på Bispebjerg Hospital, følge processen og lave kunstværket af hvad der findes i forvejen. Mere info findes på Camilla Nørgård’s hjemmeside: www.camillanorgaard.net/bispebjerg-hospital
**Det Bæredygtige Forsamlingshus’s hjemmeside: detbaeredygtigeforsamlingshus.dk Tilmelding via Billetto: Masterclass: Dont Look Forward Look Around


















-----------------------------------------------------------
Masterclass: Dont Look Forward Look Around af Billedkunstner Camilla Nørgård
2. + 9. april 2025 kl.17-18.
Masterclassen er en introduktion til ægtempera, som er en maleteknik fra før oliemaleriet blev opfundet. Vi skal lave bindemiddel med æggeblomme, blande det med mineralske farvepigmenter og undersøge nogle af deres egenskaber i maleri. Grundprincipperne omkring brugen af farve minder om dem, man anvender i traditionel ikonmaleri.
Ved masterclassen er der alt, hvad vi skal bruge til at komme i gang, og I kan få opskrifter med hjem.
Billedkunstner Luise Noora Sejersen's hjemmeside: luisesejersen.dk


Masterclass
19.03.2025 & 26.03.2025
Ægtmperamaleri ved billedkunstner Luise Noora Sejersen
















-----------------------------------------------------------
Hvis man dykker bare lidt ned under overfladen i videnskaben, finder man hurtigt ud af at der ikke er enighed om definitionen på liv. Nogle definitioner går i retning af grundstoffer der skal være til stede, nogle sætter fokus på bevægelse. Andre ser på reproduktion, og yderligere andre kigger på stofskifte. Det bliver tydeligt, at det kommer an på hvilket lys vi ser vores omverden i. Er det muligt at se på alt hvad der virker i verden som levende på sin egen måde? Kan man betragte plastik som levende? Er teknologier en del af livets kredsløb? Det er bare et par af de spørgsmål Studio ThinkingHand undersøger i deres installations- og videoværk Intertidal Synthesis, hvor silikonerobotter sættes ud i tidevandsområder, for at leve deres liv mellem ebbe og flod sammen med krabber, muslinger, mudder og sten. Til denne workshop i vil Rhoda og Mikkel fra Studio ThinkingHand, tage os med ind i de bløde robotters verden, og gennem en række øvelser vise os hvordan man koder og arbejder med robotter der i sin iboende materialitet kan relatere til sine omgivelser.
Du kan se denne video om Studio ThinkingHands arbejde med bløde robotter:
https://youtu.be/5lwpXK9u7xQ
Og deres hjemmeside:
https://studiothinkinghand.com


18.04.2024
Masterclass med bløde robotter af Studio ThinkingHand
-----------------------------------------------------------
PERFORMING-MASTERCLASS: "KROPPEN SOM BÆREDYGTIGT KUNSTMATERIALE" AF KUNSTNER SKYE JIN.
12 oktober 2023
Tilmelding skal ske via Billetto: https://billetto.dk/.../masterclass-i-baeredygtig...
Kunstner Skye Jin vil på en sjov, tankevækkende og engagerende måde guide os igennem tre forskellige måder at lave kunstneriske performances på: at performe sammen med andre, at instruere publikum eller andre performere og at performe solo og bruge sin egen historie som materiale. Vi kommer til at lave en række øvelser omkring samarbejde, krop, tid, tekst og at også bruge performance i produktion eller aktivering af skulptur og installation. Der vil også være mulighed for at snakke om eksperimental teater og antropologiske aspekter af det at performe i mange kulturer og rig mulighed for gruppe refleksion, feedback og til sidst at lave performance for hinanden. Det anbefales at orientere sig på http://gardeningisactivism.dk/for at se eksempler.
Skye Jin har 20 års erfaring med at arbejde performativt på mange måder: som kollektiv, sanger og skuespiller, med performance som social skulptur, durational performance, med publikum og med at instruere andre performere.
Medbring gerne kunstprojekter, betydningsfulde objekter eller materialer du er i gang med lige nu, hvis du gerne vil arbejde med dem på en performativ måde. Tag varmt tøj på da vi går ud på hospitalgrunden under selve masterclassen.
Masterclassen er en del af et forberedende forløb som munder ud i en bæredygtig kunstkonkurence i 2024 ved Det Bæredygtige Forsamlingshus på Frederiksberg, som man har mulighed for at deltage i. Forløb og konkurence er i et samarbejde med Frederiksberg Kunstnerlaug og finanseret af Frederiksberg Fonden
Program:
17-19 Masterclass med Skye Jin
19-20 Gratis aftensmad for de deltagende
20-22 Mulighed for at arbejde videre med det vi har lært (uden Skye Jin)



-----------------------------------------------------------
---------------------------------------------------------------------------------------------------------------------------------------------------------------------------------------
BÆREDYGTIG KUNSTMASTERCLASS
ved BILLEDKUNSTNER VERONICA RIGÉT
i samarbejde med Aftenskolen oplev Frederiksberg
Tilmelding til oplægsdelen og/eller workshopsdelen gøres ved at krydse af i deltager
Tilmelding kun til workshoppen (herunder også oplæg og debat delen) skal også gøres ved at tilmelde sig på Billetto som kan gøres via dette link:
https://billetto.dk/.../baeredygtig-kunstworkshop-3...
Kan man bruge kunsten til innovativ bæredygtighed? Det kan I blive klogere på og eventuelt også være med i debatten i de bæredygtige kunstworkshops ved Det bæredygtige Forsamlingshus på Frederiksberg. Utroligt mange kunstnere arbejder i spændingsfeltet mellem bæredygtighed og kunst.
Torsdag d.17/8 kl 17.00 kan du møde billedkunstner Veronica Rigèt som vil holde et lille oplæg om bæredygtig kunst og materialer med en efterfølgende workshop. Ved workshoppen vil der blive arbejdet med tempera, isomalt og selvhærdende modelleringsmasse og du vil selv kunne afprøve. Dette er den tredje bæredygtige workshop af i alt seks.
Veronica Rigét arbejder med forgængelighed, menneskets forhold til naturen, og det ambivalente forhold, vi har til naturen i os selv. Hun har blandt andet deltaget i udstillinger på Kunsthal Charlottenborg, Horsens fængselsmuseum, KØS, Bergen Rådhus og Sophienholm. Veronica Riget på Instagram: https://www.instagram.com/veronicariget
Torsdage aftener i løbet af efteråret 2023 vil du kunne deltage i oplæggene og/eller de efterfølgende workshops. Du er velkommen til kun at deltage i oplæggene med debat fra kl. 17:00 og ca en halv time frem helt kvit og frit, men det er nødvendigt med tilmelding til de efterfølgende aktiviteter efter oplæg og debat hvor der også vil være lidt mad.
Program:
17.00 Oplæg og debat med Veronica Rigèt om bæredygtig kunst og materialer.
17.30 Workshop med Veronica Rigét om tempera, isomalt og selvhærdende modelleringsmasse.
19.00 Mad for dem som deltager i den efterfølgende workshop.
19.30 Der arbejdes videre med de bæredygtige materialer uden Veronica Rigèt og man kan blive resten af aften selvom der står at det slutter kl. 20.00.
Arrangementerne er gratis, og du kan tilmelde dig til workshoppen med Veronica Rigèt torsdag d.17/8 via Billetto linket øverst på siden.















